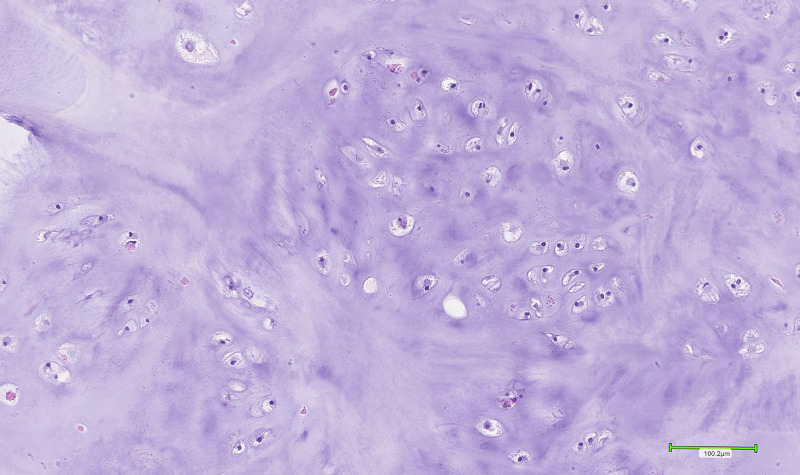

来源:医博士 | 2021-09-06 作者:耳鼻喉
软骨瘤是良性软骨肿瘤,通常发生在手和脚的小骨头。头部和颈部的软骨肿瘤很少见。在报告的病例中,大多数发生在筛窦和上颌骨。本文报告一例鼻中隔软骨瘤。自1842年以来,文献中仅报道了有限数量的鼻中隔软骨瘤。这些患者常有鼻塞、鼻出血、周围结构受压等症状。影像学和组织病理学技术已被运用于区分软骨瘤和恶性肿瘤,如软骨肉瘤。
病例介绍
一位55岁男性因可疑的鼻中隔和鼻小柱生长性病变就诊。新生物质硬,并伴有鼻中隔远端肿胀。由于既往未经治疗的鼻部骨折,鼻中隔严重偏斜。在局麻下对病变进行穿刺活检,显示坏死软骨碎片,无恶性肿瘤。由于病灶持续增大,行全身麻醉下手术切除。切除的新生物尺寸为2.5x1.5x1.1cm,送病理检查。
大体检查发现新生物为粗糙的息肉样硬棕白色病灶,类似软骨肿瘤。病理组织学检查显示一个界限清楚的肿瘤,由分叶状成熟透明软骨组成,细胞数量略有增加。软骨样基质均匀分布在由纤维间隔分隔的小叶内(图1)。大多数软骨细胞排列在单个骨陷窝中,呈淡黄色,单个均匀的小细胞核,周围有透明至嗜酸性的细胞质(图2)。还鉴定了双核软骨细胞(图3)。无缺血改变、明显多形性、有丝分裂或坏死迹象。这与良性软骨样肿瘤的特征相一致,而不是低度软骨肉瘤。

图1
图2

图3
讨论
鼻中隔软骨瘤很少见。在这些罕见的病例中,60%发生在50岁以下的患者,最常见的年龄组是成年早期。
鼻腔软骨瘤通常由其坚硬光滑的质地、分叶状外观和边界清楚界定。由于这些特点,他们可能被误诊为鼻息肉。显微镜下可见小的软骨细胞、苍白的空泡状细胞质、小的暗染细胞核和双核软骨。鼻腔软骨瘤也可表现为周围皮质骨的侵蚀。相关症状包括鼻塞和鼻出血。尽管其惰性特征,但如果体积过大大,会对上颌骨和眼眶造成压力效应。
恶性肿瘤发病率是良性软骨肿瘤的两倍。因此,鉴别软骨瘤和软骨肉瘤必须慎重。恶性特征,如坏死、多形性或有丝分裂应排除。特别是应确定异细胞增多等因素,因为它们可能表示从软骨瘤到低度软骨肉瘤的过渡阶段。
关于软骨瘤的起源有许多理论。这包括细胞静止理论,该理论认为软骨瘤起源于软骨内骨化过程中未被再吸收的胚胎软骨。另一种理论,创伤理论,将发病机制归因于过去的创伤和愈合过程。虽然创伤性理论被许多人驳斥,但本文报告的病例是一例因未经治疗的鼻骨骨折导致鼻中隔偏曲的患者。因此,创伤和鼻软骨瘤的发生之间的联系应该被考虑。
鼻腔软骨瘤的诊断包括影像学和组织病理学检查。CT扫描用于评估软骨瘤生长情况,软骨瘤边界清楚且同质。建议多部位活检,因为软骨肉瘤可能仅局限于局部。
小结
手术切除是首选的治疗方法,根据受累鼻中隔的不同情况,可采用不同的方法。软骨良性肿瘤对放射治疗有抵抗力,但恶性肿瘤可考虑放射治疗。在罕见的病例中(5%),软骨瘤可以转化为恶性肿瘤。术后复发率预计为10%-15%,因此建议长期随访。
医博士编译自:Peer M, Tibbo J, Kao K, et al. Chondroma of the Nasal Septum. Cureus. 2021; 13(1):e12941. doi:10.7759/cureus.12941.
声明: 所有注明“来源:医博士”的文字、图片和音视频资料,版权均属于医博士所有,转载须注明“来源:医博士”;所有转载文章系出于传递更多信息之目的,且明确注明来源和作者,不希望被转载的媒体或个人可与我们联系,我们将立即进行删除处理。